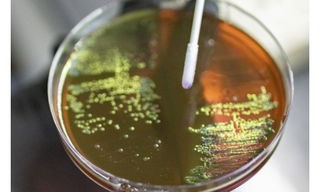

With a rise in avian influenza cases reported in parts of Kerala, including Alappuzha and Kottayam, authorities in Tamil Nadu have ...
High levels of antibiotic-resistant superbugs in both indoor and outdoor environments in Delhi are posing public health risks, according to a study. ...

The Institute of Kidney Diseases and Research Centre (IKDRC-ITS) at Ahmedabad Civil Medical College has created history by completing 500 kidney transplants in a single year, setting a new national benchmark in the public healthcare sector. ...

The government has banned the manufacture, sale and distribution of all oral formulations of pain and fever medications, containing Nimesulide above 100 milligrams in immediate‑release dosage form, with immediate effect. ...

India has delivered a consignment of six ambulances to Afghanistan, amid growing healthcare cooperation between the two countries, according to a media report. ...

Do not take antibiotics over the counter, without a doctor’s consultation, said Dr M Srinivas, Director at AIIMS, Delhi, on Monday, even as Prime Minister Narendra Modi warned against their misuse. ...

New Year is the time for many people to pledge reforms in habits and lifestyle, something resorting to drastic measures, but UK's Medicines and Healthcare products Regulatory Agency (MHRA) has urged the people to make sure any weight-loss medicines they use are safe, effective and legitimate. ...

A total of 108 laboratories have been approved for quality testing of Ayurvedic, Siddha and Unani drugs, said Ayush Minister Prataprao Jadhav. ...

The Ministry of Ayush has signed 25 country-to-country level MoUs for cooperation in the field of Traditional Medicine and homoeopathy,...

A father’s exposure to microplastics can trigger metabolic dysfunctions in children, with daughters more at risk of developing diabetes, according to animal studies. ...